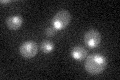
YLR278C
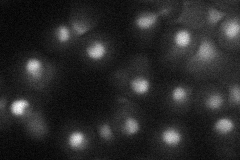
YLR278C
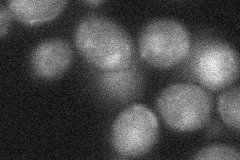
YLR278C

View description
Zinc-cluster protein; GFP-fusion protein localizes to the nucleus; mutant shows moderate growth defect on caffeine; has a prion-domain like fragment that increases frequency of [URE3]; YLR278C is not an essential gene
Localization:
Intensity:
Fold change:
Significance:
-
C’ GFP library in SD
nucleus22.36 -
N' NOP1pr-GFP in SD

nucleus33.2868 -
N' TEF2pr-mCherry in SD
nucleus20.3139 -
N' NATIVEpr-GFP in SD

nucleus22.8827 -
N' TEF2pr-VC and Cyto-VN in SD
nucleus27.9471 -
C’ GFP library in SD+DTT

nucleus17.510.78Yes -
C’ GFP library in SD+H2O2

nucleus24.721.1No -
C’ GFP library in Starvation Media

nucleus18.460.82No -
C’ GFP library on the background of Pup2-DaMP

nucleus -
C’ GFP library on the background of CCT mutant

nucleus22.66181.0133No
